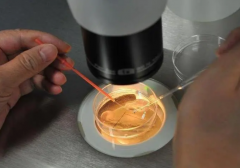
未知养囊数下的希望之光：双囊胚移植成功率挑战50%大关

胚胎移植

-
 试管:为何双胚胎植入仅成活一个?
试管:为何双胚胎植入仅成活一个?试管可以简单地理解为通过试管受精的婴儿,是一种辅助生育技术,它可以帮助不孕不育的夫妻解决生育问题,而且在放置试管时,一般要放两个才行,那么为什么试管放2个就成
作者:木易 126 发布时间:2024-08-13 -
未知养囊数下的希望之光:双囊胚移植成功率挑战50%大关
未知养囊数下的希望之光:双囊胚移植成功率挑战50%大关试管技术已经成为不孕不育夫妇的一种重要选择,而在进行试管前,最关键的步骤就是胚胎培养,因为这直接影响了胚胎的质量和成功率。然而在进行胚胎培养时,有时候6个胚胎不能
作者:婷婷 172 发布时间:2024-08-13 -
 一个囊胚移植后可能诞生双胞胎?——三代试管技术生双胎的优劣势探
一个囊胚移植后可能诞生双胞胎?——三代试管技术生双胎的优劣势探试管技术是一种通过体外受精,将受精卵培养到一定阶段后再将其移植回母体内妊娠的生殖医学技术。那么三代试管植入一个囊胚能生双胞胎吗? 试管双胞胎有哪些优缺点? 1、优点:试管
作者:婷婷 194 发布时间:2024-08-13 -
 试管胚胎移植后是否需要住院?了解其决策背后的原因
试管胚胎移植后是否需要住院?了解其决策背后的原因试管技术是近年来备受关注的生殖医学技术,对于许多不孕不育的夫妇来说,这是一种重要的生育方式。在试管中,放置胚胎是一个至关重要的步骤。那么在这个过程中,需要住院吗
作者:wednesday 132 发布时间:2024-08-12 -
 18号染色体异常危害性大,主要由四大原因引起
18号染色体异常危害性大,主要由四大原因引起胚胎18号染色体异常是指在胚胎发育过程中,18号染色体出现了异常。这种异常的出现可能会对婴儿的健康产生影响。本文将介绍四大原因,以及为什么不建议要。 导致胚胎18号染色体异常的原
作者:木易 105 发布时间:2024-08-12 -
 试管移植后:推荐食用的肉类种类及需规避的肉类
试管移植后:推荐食用的肉类种类及需规避的肉类试管移植是一项较为复杂的医疗技术,需要注意饮食和生活习惯等方面。很多夫妇在进行试管移植手术后都会有各种疑惑,其中就包括饮食问题。那么试管移植后可以吃什么肉呢
作者:wednesday 192 发布时间:2024-08-12 -
 试管移植后无显著反应怎么应对?原因探析与解决方案全览
试管移植后无显著反应怎么应对?原因探析与解决方案全览试管移植是一种常见的生殖技术,能够帮助不孕症患者实现梦想,有效地实现无孩子家庭的“补充”。然而,有时候,试管移植后会出现没有反应的情况,这可能是试管移植的失败。 移植后没
作者:wednesday 196 发布时间:2024-08-11 -
 移植13天,宝宝终于找到‘家’了?
移植13天,宝宝终于找到‘家’了?试管移植是一种辅助生殖技术,通常在排卵期,进行,将受精卵移植到女性子宫内,帮助怀孕。在成功的案例中,受精卵会在几天内着床并开始发育。然而,有些女性可能会在试管移植后的
作者:木易 108 发布时间:2024-08-11 -
 再迷茫!试管移植方案选择指南在这里!
再迷茫!试管移植方案选择指南在这里!试管是一种技术性的辅助生殖技术,它能够帮助那些未能通过正常性生殖的夫妇,通过试管的技术来实现梦想中的家庭。本文将介绍试管移植方案的区别,并讨论它们在不孕不育
作者:木易 61 发布时间:2024-08-11 -
 试管移植成功关键:掌握这些指标,精准判断好孕迹象!
试管移植成功关键:掌握这些指标,精准判断好孕迹象!试管移植是一项先进的辅助生殖技术,通过它,即使在实现自然受孕无法的情况下,也可以实现梦想的幸福家庭。在移植过程中,孕妇接受受精卵的移植,最终能否成功依赖于多种因素,
作者:婷婷 107 发布时间:2024-08-11 -
 做试管前必看!移植流程大揭秘,助你顺利迎接宝宝!
做试管前必看!移植流程大揭秘,助你顺利迎接宝宝!试管移植,是一种能帮助治疗不孕不育的一种医疗技术,它能够帮助患者获得梦寐以求的孩子,也给患者带来希望。试管移植流程包括卵子取取、受精、胚胎发育和移植等几个步骤,
作者:木易 129 发布时间:2024-08-11 -
 如何选择合适的试管胚胎移植时机?如何提高试管的成功率?
如何选择合适的试管胚胎移植时机?如何提高试管的成功率?试管是一种辅助生殖技术,可帮助无法自然受孕的夫妇实现生育愿望。但是要想成功地进行试管,需要注意许多细节和因素。下面将回答几个与试管相关的问题。 试管百分百
作者:盼盼 184 发布时间:2024-08-10
